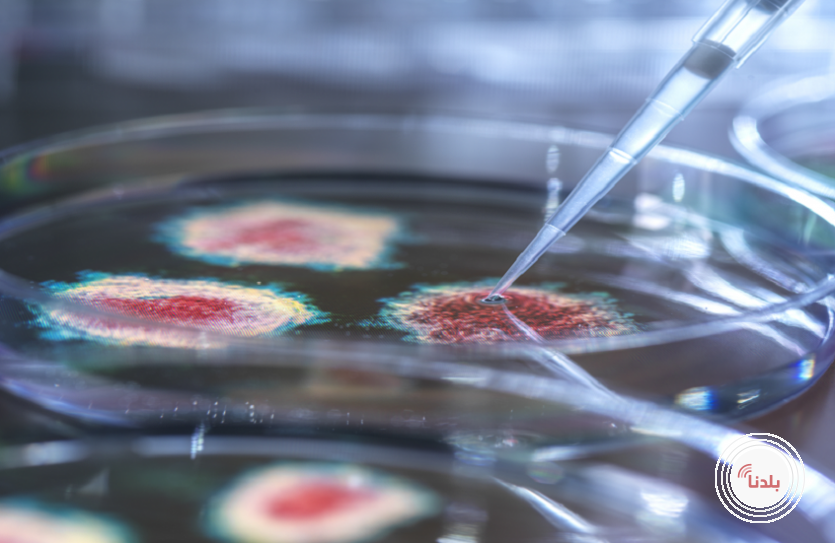

مركبات طبيعية تحارب حمى الضنك وتعزز الدم
بلدنا-أعلنت جامعة جنوب الأورال الحكومية الروسية أن علماء من روسيا والهند توصلوا إلى اكتشاف يساعد أجسامنا على مقاومة حمى الضنك وبعض الأمراض الأخرى.
وقالت الخدمة الصحفية لجامعة جنوب الأورال الحكومية الروسية في بيان لها: "قام علماء من الجامعة، بالتعاون مع المعهد المركزي لبحوث الأدوية في الهند، بدراسة تأثير مركبات الفلافونويد الموجودة في البابايا (Carica papaya L) على مستوى الصفائح الدموية في دم الأشخاص المصابين بحمى الضنك، وتمكنوا من اكتشاف الآلية التي تساعد بها مستخلصات البابايا في مكافحة الحمى النزفية".
وأوضح البيان أن الباحثين عزلوا في عصير البابايا مجموعة من المواد متعددة الفينولات (Polyphenols)، منها الجزء النشط حيويًا من البيوتانول (BBF) والجزء النشط حيويًا من الإيثانول (BEF). وأظهرت النتائج أن هذه المواد تحفّز نمو الصفائح الدموية في دم المرضى، كما تعزز تكوين الدم بشكل عام، بما في ذلك خلايا الدم الحمراء والصفائح وخلايا الدم الأخرى، مما يساهم في إنقاذ حياة المرضى. كما ثبت أن BBF فعّال أيضًا في تدمير خلايا سلسلة HepG2 المرتبطة بأورام الكبد لدى الإنسان، وهي الخلايا التي يمكن لفيروس حمى الضنك أن يخترقها بسهولة.
وأظهرت الدراسات أيضا أن مركبات نباتية أخرى في عصير البابايا، مثل الكيرسيتين، وحمض الترانسفيروليك، والكامبفيرول، تقلل من نقص الصفائح الدموية. كما يمتلك الكامبفيرول تأثيرا قويا مضادا للالتهابات من خلال خفض مستويات أكسيد النيتريك في الدم.
وبناء على هذه النتائج، اقترح الباحثون نهجا علاجيا شاملًا لرفع مستوى الصفائح الدموية في حالات حمى الضنك، يعتمد على تعديل الاستجابة المناعية، وتعزيز التأثير المضاد للأكسدة، والاستفادة من الخصائص المضادة للتخثر لمكونات عصير البابايا.
المصدر: تاس